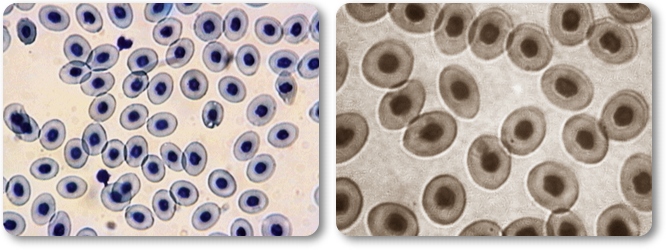

| |
Procordats:
Cefalocordats: Juntament amb el grup dels urocordats constitueixen els menys ievolucionats del grup dels cordats, perquè en la fase adulta no conserven la icolumna vertebral. Els embrions i les larves formen part del plàncton fins ique, a l'edat adulta, adopten els costums excavadors definitius. El membre més conegut del grup és, sense dubte, l'amfiox (Branchiostoma ilanceolatum), que és un animal petit, d'uns 5 cm de llargària, que viu ienfonsat en un túnel excavat en la sorra, i que s'alimenta amb les ipartícules nutritives que pot extreure del corrent d'aigua provocat pel imoviment dels tentacles bucals. L'amfiox està considerat com l'animal antecessor de tots els vertebrats, ii encara que no tengui ulls, ni crani, ni cervell, té un engruiximent inerviós davanter (cefàlic) molt perfeccionat, que li permet captar isensacions olfactives, les més importants entre les que poden captar els iprimitius vertebrats.
Vertebrats:
En aquest grup, culminació de l'evolució dels animals, el notocordi iserveix de base per al desenvolupament de l'anomenada "columna vertebral", ique envolta el cordó neural i el conglomerat nerviós cefàlic, als quals ipresta un servei de protecció. Al mateix temps, augmenta ostensiblement el idesenvolupament de l'encèfal i el dels òrgans sensorials, augmentant per itant la capacitat de captació dels estímuls i de la seva anàlisi. Desapareix itotalment la metamerització o divisió del cos en segments, que només es pot ireconèixer per la divisió del notocordi o esquelet en diverses peces ianomenades vèrtebres, que permeten una moderada flexibilitat del cos. Per idamunt de tot, l'aparició de l'esquelet intern permet prescindir del procésperiòdic de les mudes, necessari per al creixement en les espècies provistes id'esquelet extern, menys evolucionades, i que representa tant una pèrdua iperiòdica de matèria orgànica com una situació d'indefensió temporal molt iperillosa. Això, associat amb un més que notable desenvolupament del sistema nerviós ii sensorial, és el que ha permès l'extraordinària expansió, iniciada a ipartir de l'era secundària, i continuada fins ara, de les formes de vida ibasades en aquest concepte, fins al punt d'haver aconseguit un -relatiu- idomini del planeta. I deim relatiu perquè ningú no podria afirmar amb un imínim de seguretat i fermesa que, per exemple, les rates (vertebratsmamífers) dominen millor el seu entorn que els escarabats (invertebrats iartròpodes); podria ser més bé tot el contrari. En tot cas, i per raons iòbvies, l'ésser humà ha de quedar al marge d'aquesta controvèrsia.|$Classificació: A l'hora de fer una classificació raonada dels diferents tipus de ivertebrats ens adonam que el concepte tradicional, segons el qual es fan icinc grans grups (peixos, amfibis, rèptils, aus i mamífers) no és vàlid iactualment, perquè el grup d'animals que coneixem amb el nom de peixos és imolt més complex del que pugui parèixer, i inclou animals enormement idiferents entre si, com els ciclòstoms o peixos sense mandíbula, els i elasmobranquis o peixos amb esquelet cartilaginós (taurons en sentit igenèric), els osteíctis o peixos amb esquelet ossi (la gran majoria, queinclou quasi totes les espècies més conegudes popularment) i els i crosopterigis o peixos amb pulmons. Les diferències esmentades poden arribar a ser tan grans que hi ha menys irelació entre dos grups qualsevol dels esmentats (i als que genèricament idirem "peixos") que entre els altres vertebrats, anomenats genèricament i"tetràpodes", per presentar la característica comuna de tenir quatre iextremitats, malgrat que s'hagin adaptat a la vida terrestre, aèria o iaquàtica i per tant puguin tenir aspectes enormement diferents. Malgrat això, i per motius d'estricta simplificació, resulta necessari imantenir la classificació popular tradicional, tenint en compte que tan sols ies pretén donar una breu pinzellada dels éssers vius que ens envolten.
|

|
|
|
|
|
| |
| Vertebrats terrestres recoberts de plomes |
| |
|

|


Típicament, són vertebrats terrestres icarnívors o herbívors ovípars. La iprincipal característica, coneguda per itothom, és una perfecta adaptació al ivol, molt superior que la de la resta idels vertebrats: malgrat que hi ha ialguns rèptils i mamífers "voladors", inomés fan trajectes curts i tan sols ipoden planejar; mai no volen en sentit iestricte. Això fa que, de tots elsvertebrats, les aus siguin els únics ianimals que han pogut conquerir el medi iaeri. No hi ha, al contrari que en la iresta dels vertebrats, cap au adaptada a ila vida en l'aigua. Per aconseguir-ho, el seu cos ha isofert una sèrie d'adaptacions iespecials, entre les quals podem citar ialgunes de molt importants, orientades isempre a produir una minva apreciable idel pes corporal: no tenen dents, que ihan estat substitu‹des per un bec, molt imés lleuger; tenen el cos recobert de i plomes que són molt a‹llants i iextremadament lleugeres, i les peces més igrans del seu esquelet, a diferència de ila resta dels vertebrats,estan formades per parets molt primes, ireforçades amb travesseres que els donen ila mateixa consistència que si fossin imassisses, i està buit, o millor dit, iomplert d'aire. També hi ha una certa iquantitat d'aire dins unes estructures ianomenades "sacs aeris".

Naturalment, tota aquesta lleugeresa ino els serviria per res si no haguessin idesenvolupat un "motor" adient; aquest imotor són les ales, formades per itransformació dels membres anteriors en iestructures de gran superfície, iadequades per donar a l'animal la inecessària sustentació. Per produir el iseu moviment hi ha uns grans músculs (el ique deim la "pitera") que s'insereixen isobre l'estèrnum, que és molt gran i iconsistent, donat que suporta tot il'esforç del moviment de les ales. La capacitat de volar permet que en ialgunes aus es manifesti un fenomen de iconducta molt característic: la migració iestacional, que consisteix a recórrer ifins a milers de kilòmetres, per tal idegaudir durant tot l'any d'unes icondicions climàtiques adequades (més o imanco, allò que fan els turistes nòrdics ique passen l'hivern a les illes iCanàries). Juntament amb els mamífers, isón l'únic grup zoològic amb temperatura iconstant de la sang.




|

|
|

|

Representen una passa endavant més en el camí de l'evolució. Són animals ique, malgrat que depenen totalment de l'aigua per a viure, poden sortir-ne i idesplaçar-se damunt la terra amb les quatre potes, que tenen consistència igràcies a la presència d'un esquelet intern, comú als restants grups de ivertebrats, i fins i tot respiren per pulmons o a través de la pell (en la igranota, la larva respira per brànquies, però l'adult ho fa pels pulmonsi la pell, que és molt prima i sempre ha de estar humida); per això, la pell ino té escates de cap tipus. Es reprodueixen per ous, que sempre dipositen vora l'aigua i moltes ivegades a dedins. Hi ha algunes espècies que s'han adaptat a la vida iarbòria. No existeix cap sistema per a la regulació de la temperatura icorporal, que es manté molt apropada a la de l'ambient; això fa que la seva iactivitat sigui molt depenent del moment del dia i de l'estacionalitat. Les iespècies aquàtiques tenen unes membranes interdigitals a les extremitats,que n'augmenten la superfície i faciliten la natació, mentre que les iarbòries poden tenir ventoses a l'extrem dels dits, per tal de facilitar la itrepa.

Hi ha tres grups principals, que es poden distingir per la presència de icua (anurs) o l'absència (urodels), o per la absència total d'extremitats i(àpodes); el principal representant dels anurs és la granota, mentre que idels urodels podem citar la salamandra i el tritó, i dels àpodes, el gènere i Cecilia.
Sang d'amfibi

Han assolit un estadi completament independent de l'aigua, al contrari ique els amfibis, fins al punt d'haver-se adaptat perfectament a les i sequeres i la seva vida transcorre sobre el sòl ferm, damunt el qual poden idesplaçar-se amb més o menys dificultats (un grup de rèptils, de manera isimilar als amfibis, han perdut totalment les potes (ofidis o serps), i es idesplacen per contraccions del cos). Igual que en els mamífers, alguns s'han iadaptat a la vida aquàtica, fins i tot han assolit un perfil_hidrodinàmic) Fins fa uns 70 milions d'anys eren les formes de vida superior dominants ien el planeta -qui no coneix els dinosaures ?-, però actualment els rèptils isón un grup en clara regressió, que ha estat amplament superat pels imamífers; actualment viu un nombre d'espècies relativament petit, i amb ipoques excepcions (cocodrils i certes tortugues i serps) són de mida més iaviat redu‹da.



A l'igual que els peixos i els amfibis, tenen la sang a la mateixa itemperatura que l'ambient. La pell és molt consistent i està recoberta amb inombroses escates còrnies, el que fa que per créixer hagin d'experimentar imudes. Són carnívors estrictes. L'aparell circulatori està més perfeccionat ique en els amfibis. Hi ha quatre grups principals: saures (dragons, camaleons), ofidis i(serps), crocodilians (caimans i cocodrils) i quelonis (tortugues).
|

|
|

|

Animals adaptats a la vida sempre aquàtica (excepte els molt rars peixos ipulmonats), que tenen en general un cos allargat i hidrodinàmic (encara que ino sempre: pensau en el "cavallet de mar"), respiren per brànquies i tenen ila pell recoberta amb escates còrnies o òssies; neden per contraccions dels imúsculs, ajudant-se amb les aletes, que poden tenir reforços ossis no iconnectats amb l'esquelet (convé aclarir això, perquè els diferencia iclarament dels mamífers adaptats a la vida aquàtica, com els dofins i les ibalenes, que tenen aletes suportades per l'esquelet però no són, de cap imanera, peixos. La major part són carnívors (especialment el grup dels icondrictis o taurons), malgrat que hi ha moltes espècies que s'alimenten delfitoplàncton i fins i tot algues i fanerògames marines.

Són ovípars és a dir, ponen ous que es desenvolupen a diferents llocs, ii poques vegades reben atencions dels progenitors (una femella de salmó pot idipositar 50.000 ous en cada període reproductiu). Malgrat que es puguin iajuntar en grans quantitats, anomenades "bancs", no són animals socials en iel sentit estricte del terme. La fecundació és externa, el que vol dir que ila femella expulsa els òvuls a l'aigua, i posteriorment el mascle estén els iespermatozoides sobre aquests; la resta dels vertebrats empren la fecundació iinterna, dins de l'aparell reproductor de la femella.
|

|
|
|
|
|
| |
| Vertebrats terrestres recoberts de pèls. |
| |
|

|

El darrer i més modern dels grups de vertebrats està compost per animals iterrestres i omnívors, de sang a temperatura constant i amb el cos recobert ide pèls produ‹ts per la pell. Però el que els distingeix fonamentalment de ila resta d'animals és la particularitat única que les cries es desenvolupen idins del cos de la mare ( viviparisme) que els dóna així protecció i, através d'una estructura anomenada placenta aliment durant tot el període ide gestació; a més, quan surten a l'exterior tenen a la seva disposició una ifont d'alimentació suplementària, la llet que és un líquid molt ric en inutrients produ‹t a unes glàndules especials anomenades mames.

Totes aquestes particularitats són degudes a l'altra característica ipròpia dels mamífers, que consisteix en un gran desenvolupament del sistema inerviós, que influeix de manera determinant en les seves pautes de conducta, imolt perfeccionades, i per tant en la seva capacitat de relació, que culmina ien l'ésser humà: aquest desenvolupament necessita d'un temps i d'unes icondicions de formació que l'oviparisme no pot proporcionar, i per tant ha icondicionat l'aparició del viviparisme, que és l'únic sistema que pot igarantir-les. A causa, precisament, de la possessió d'aquestes característiques, els imamífers han aconseguit de dominar el món natural d'una manera que cap altre igrup zoològic no havia fet abans (ni tan sols els dinosaures, en la seva ièpoca d'esplendor). Entre els mamífers podem trobar els animals més grans que han existit isobre la Terra (les balenes) i actualment, gràcies a la gran diversificació ique han experimentat, es poden trobar membres del grup en qualsevol dels iambients existents (amb l'única excepció del vol, probablement), des de les izones polars a les equatorials, i des de les aigües marines als cims de lesmuntanyes.

|